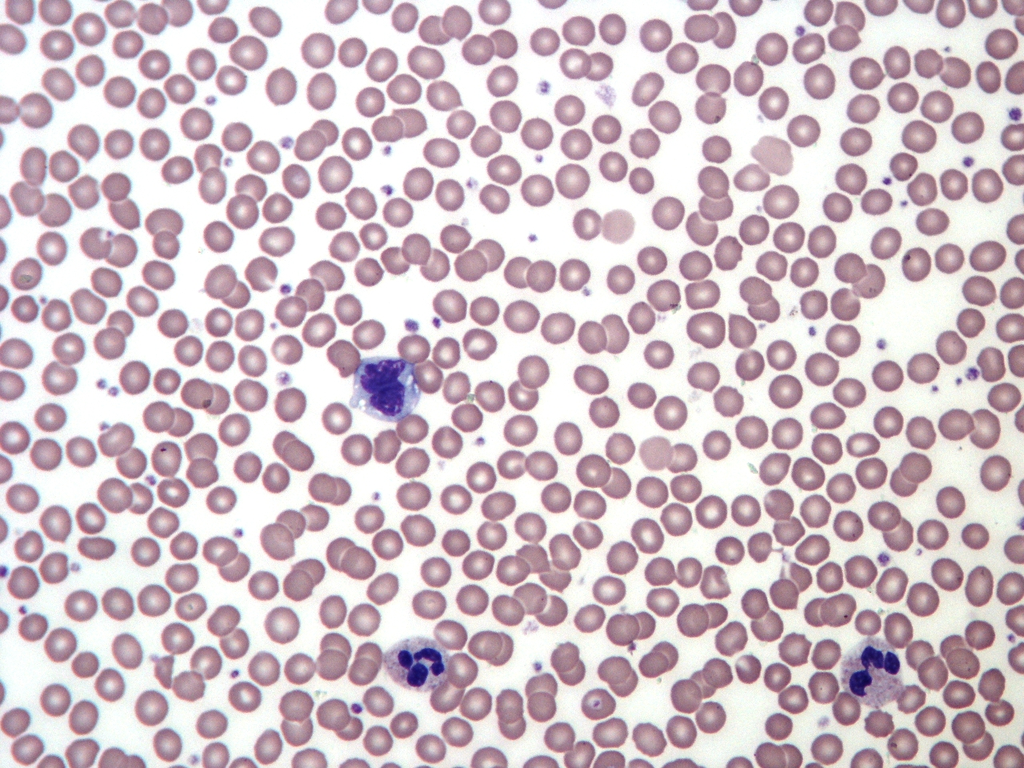
Normal Adult Blood Smear â€” Wright Stain
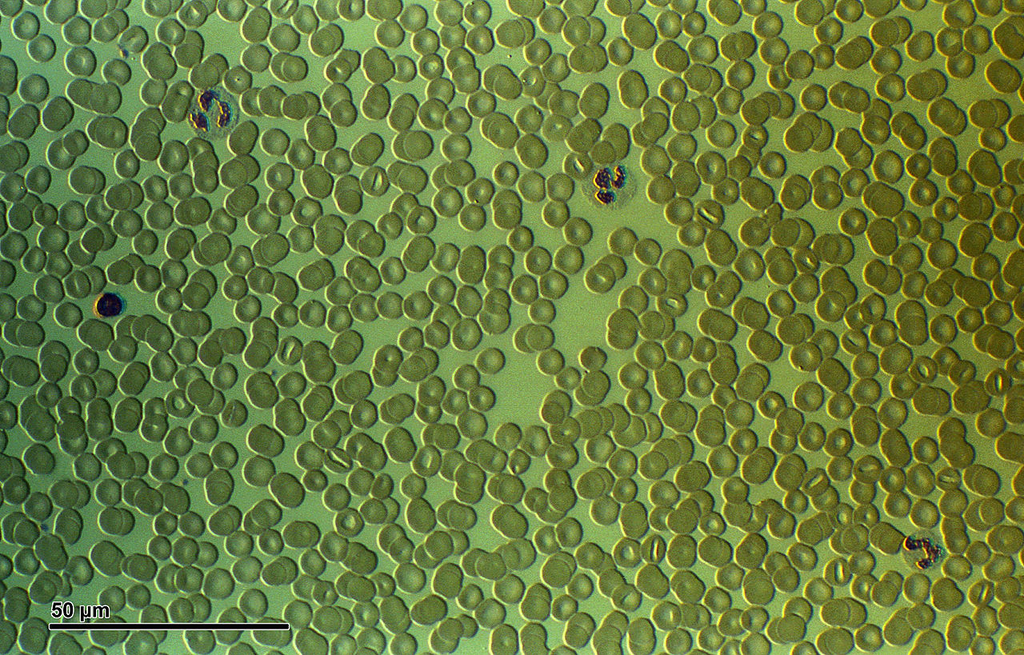
Human Blood Smear — High Resolution
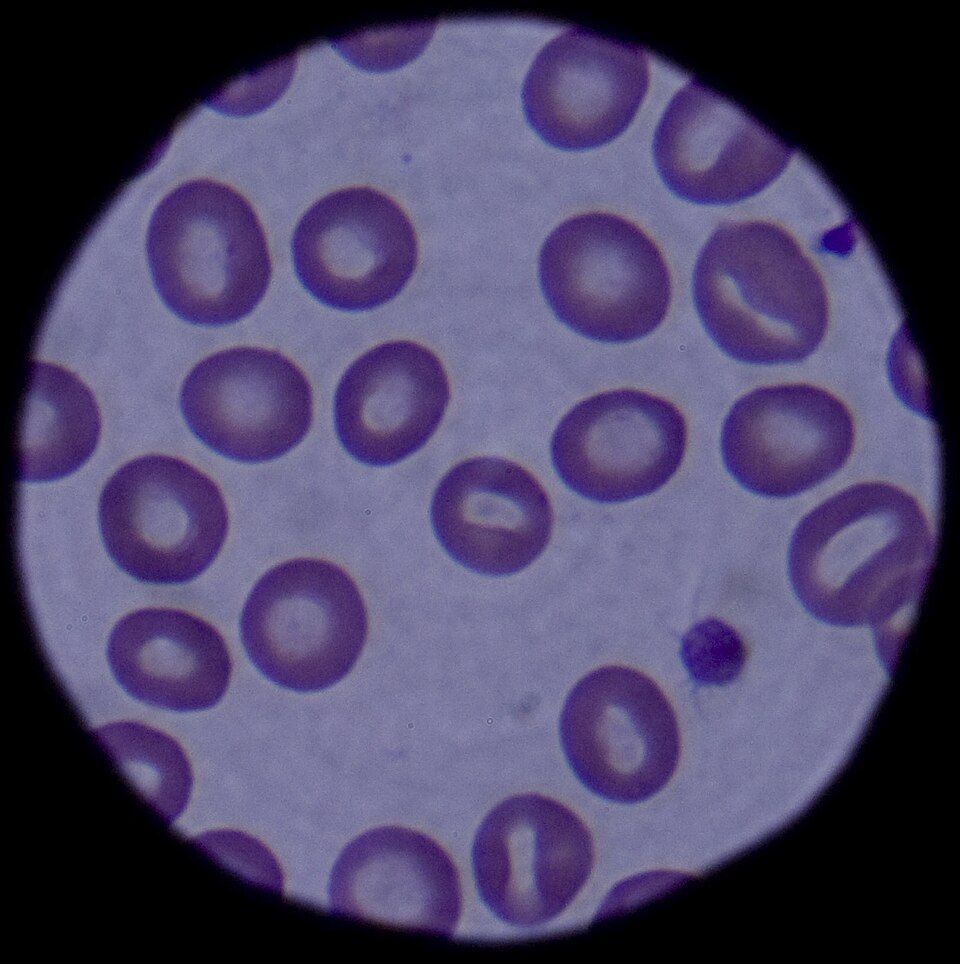
Blood Cells — Clinical Microscopy
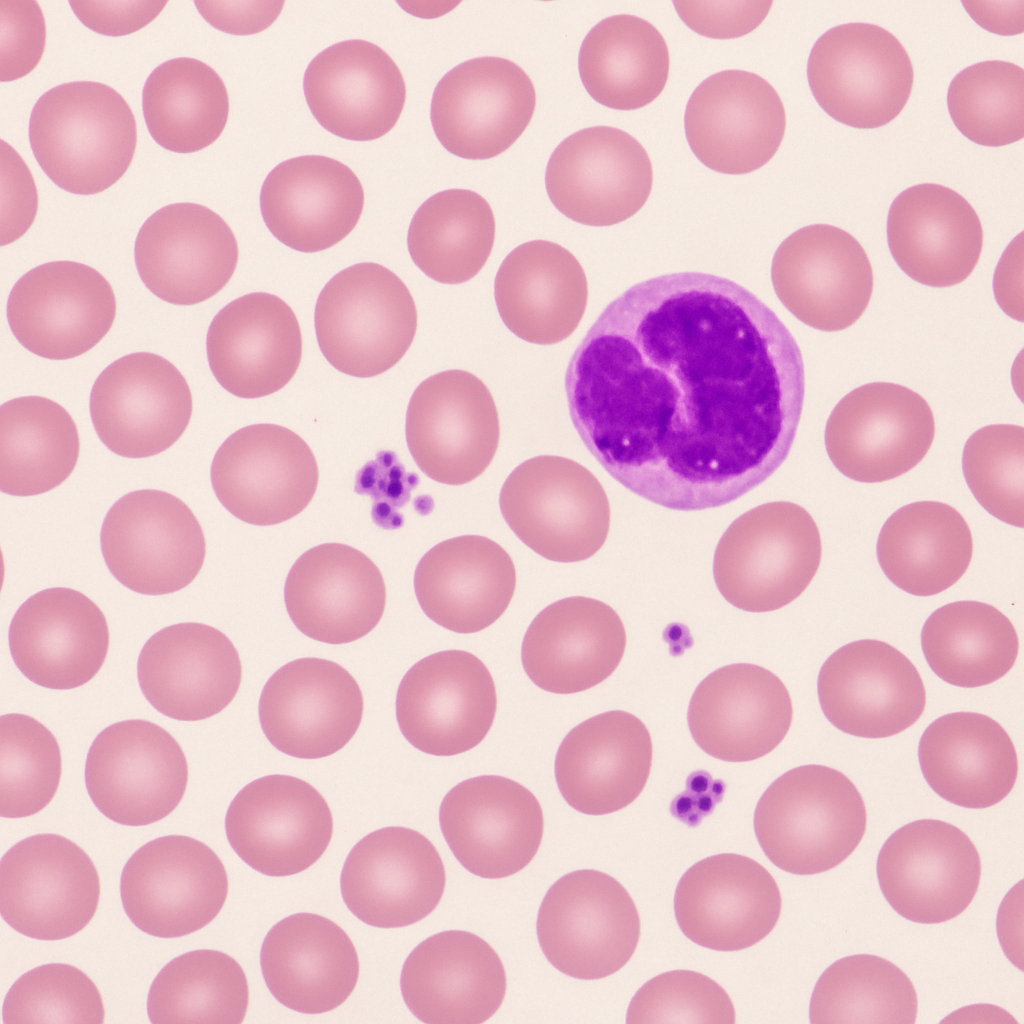
20× Intermediate Power — WBC Screening

Specimens



Urinalysis Sediment
Clinical Chemistry
Centrifuged urine sediment showing casts, crystals, and cells